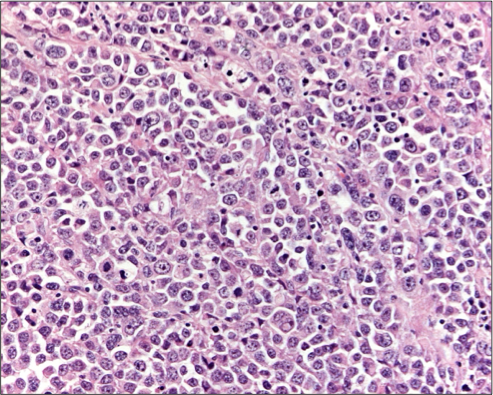

1/40
Looks like no tags are added yet.
Name | Mastery | Learn | Test | Matching | Spaced | Call with Kai |
|---|
No analytics yet
Send a link to your students to track their progress
What cells are present in the testicles and their functions?
Germ cells- arranged in seminiferous tubules -> spermatogenesis
Interstitial cells (Leydig cells): produce androgens under influence of LH
Sertoli cells:
Support germ cells in seminiferous ductules
Secrete androgen binding protein into ductular lumen and so support spermatogenesis
List the developmental abnormalities of the testes
Testicular hypoplasia
Criptorchidism
What are the features of testicular hypoplasia?
Uni or bilateral
Can be linked to toxins/ hormonal imbalances/ Zn deficiencies/ hybrids
Often associated with cryptorchid or chromasomal abnormalities
1° testicular hypoplasia occurs in several Swedish cattle breeds (recessive)

What are the effects of testicular hypoplasia?
Lack of spermatogenesis
What is cryptorchidism and its features?
Incomplete descent of testis
Abdominal or inguinal
Abdominal prone to torsion and more freq tumours
Bi- or unilateral

How does acute atrophy differ from chornic?
Acute usually only histologically
hydropic degeneration, pyknosis, multinucleate giant cells, oligo- and aspermia
Chronic reduced size and progressive fibrosis
List some of the causes of testicular atrophy
Trauma
Compression atrophy (testicular tumours)
Circulatory disorders (eg. torsion: venous infarction-> haemorrhagic necrosis)
Inflammation
Infection
Nutritional deficiencies (vits A + E)
Hyperthermia
Cryptorchidism
Ionising radiation
Hyperoestrogenism
Pituitary alterations
Senile atrophy
What are the features of testicular torsion?
Rare
Often as a sequelae to orchitis but also idiopathic
Partial vs total
Total = ischaemic necrosis

What are the names for inflammation of the testes?
Orchitis
Epididymitis
What are the general causes and features of orchitis and epididymitis
Usually infection
Purulent inflammation often due to streptococci, staph, e. coli, arcanobacterium pyogenes
Often abscess formation
What are the routes of infection causing orchitis and epididymitis?
haematogeneous-metastatic
ascending infection
external wounds
What causes orchitis and epididymitis in a horse?
Salmonella abortus equi
Equine viral arteritis (necrotising vasculitis)
What causes orchitis and epididymitis in a sheep?
Corynebacterium pseudotuberculosis and
Yersinia pseudotuberculosis (via ticks, infected from rodents)
Brucella ovis (infectious epididymitis in sheep) -> chronic epididymitis

Suppurative epididymitis^
What causes orchitis and epididymitis in a dog?
E. coli, Proteus
Brucella canis:
Mainly chronic epididymitis; spermatic
Ag can get access to blood stream with macrophages, inducing Ab against sperm (= autoimmune disease)

^Chronic granulomatous orchitis
What causes orchitis and epididymitis in a cattle?
brucellosis (B. abortus)
tuberculosis
chronic inflammation: in ruminants often associated with dystrophic calcification

^Chronic granulomatous orchitis
List the types of testicular tumours
Seminoma (germ cell tumour)
Sertoli cell tumour
Interstitial (Leydig) cell tumour
Teratoma (not in dogs, most frequent testicular tumours in horses)
What tumour is this?

Seminoma
Gross: white and soft replaced most testicular parenchyma
Hx: can be diffuse or intertubular (this one is diffuse), large round poorly differentiated cells
Benign
What tumour is this?


Sertoli cell tumour
Gross: firmer and better differentiated, white
Hx: intertubular tumour (can also be diffuse)
What clinical signs are associated with sertoli cell tumours?
Signs of feminisation (oestrogen production from tumour)
Bilateral alopecia
Cutaneous hyperpigmentation
Atrophy of opposite testis
Pendulous prepuce
Varying degrees of gynecomastia

Attraction of male dogs
Bone marrow suppression
Squamous metaplasia of prostate gland epithelium
What is being shown here?

Seminiferous tubule atrophy
What are the gross features of an interstitial cell tumour?
Soft, yellow to orange, well demarcated, bulging cut surface often with haemorrhage + cystic spaces
Usually not larger than 1-2 cm in diameter (dog)
Very rare metastases
Usually benign
What can interstitial tumours cause?
Inc androgen production maybe
Inc incidence of tumours of androgen-responsive circumanal (perianal, hepatoid) glands
What tumours it this?


Gross: cysts, haemorrhage, yellow orange
Hx: haemorrhage, vacuolation (because steroid producting which presents as lipid)
What is this showing?

Testicular teratoma
What are the categories of pathology that affect the prostrate gland?
Atrophy
Squamous metaplasia
Inflammatory
Hyperplasia
Neoplasia
When is atrophy of the prostrate gland seen?
Most frequent after castration + oestrogen administration
When is squamous metaplasia of the prostrate gland seen?
With chronic infection + under the influence of oestrogen (Sertoli cell tumour), reversible
What can cause prostatitis?
Most often in dogs, association with hyperplasia
Non-specific (urinary) bacterial infections
May lead to abscess
What is being shown here?

Prostatitis (large cavities where purulent exudate would have been)
What is prostatic hyperplasia?What does it result in?
Diffuse expansion of the gland (dorsally)
Results in compression of colon + difficult defecation
Often with cyst formation + occ prostatitis
Not necessarily premalignant
What is prostatic hyperplasia associated with?
increase in level of potent androgen (5-dihydrotestosterone) within gland
What is being shown here?

Prostatic hyperplasia
What is the most common prostatic tumour?
Usually adenocarcinoma or non-differentiated carcinoma
What are the general features of prostatic tumours?
Occ in dogs (average age =9)
Malignant
Metastasise to LN, urinary bladder and periproctal connective tissue
Feels irregular upon palpation cf to hyperplasia
What is being shown?

Prostatic carcinoma
What are the anomalies of development?
Hypospadias (ventral aspect)
Epidspadias (dorsal aspect)
Persistent frenulum
What is hypospadias/epispadias?
Malformations of the urethral canal creating abnormal opening
Predisposes to UTI
Reccomend castration

What is a persistent frenulum?
A band between the ventral raphe of the penis and the prepuce.
Usually ruptures as puberty.
Renders intromission impossible.
Important in bulls and boars.

What are the different areas of inflammation of the peni?
Phalloposthitis (entire penis + prepuce)
Balanoposthitis (glans penis + prepuce)
[Note- Specific infections: see vagina (BHV-1, EHV-3) as many are spread venereally]
What are the benine tumours of the penis in bulls?
Fibropapilloma
Caused by bovine papilloma virus type 1

What tumours affect the penis of stallions?
Squamous cell papilloma (benign) (grows outwards, finger like projections)

Squamous cell carcinoma (malignant)


Sarcoids
Induced by bovine papillomavirus type 1